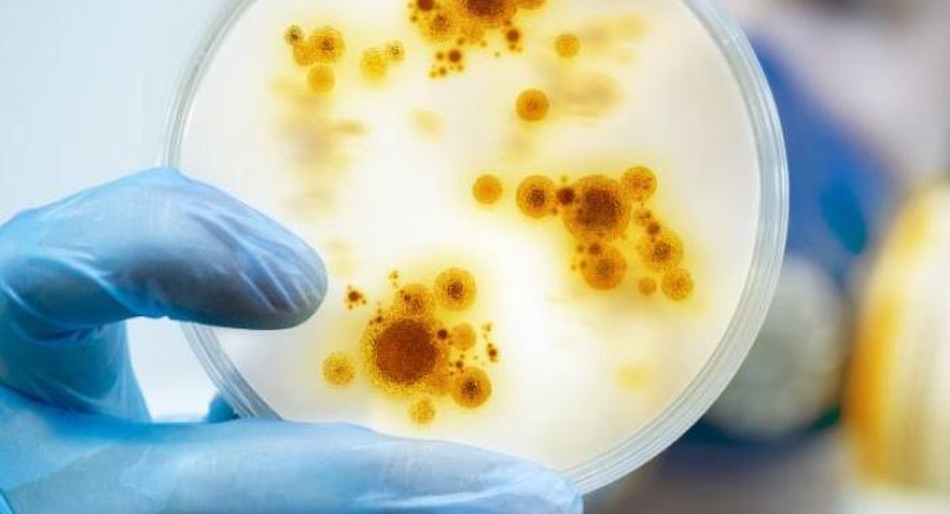

Servicios Especializados
- Banco de Sangre
- Laboratorio de Biología Molecular
- Maternidad
- Medicina Genética
- Medicina Nuclear
- Sala de Infusiones
- Centro de Entrenamiento Internacional RCP
Clínicas Especializadas
Guía de Soluciones de Salud (Blog)
San José, Costa Rica.
El Hospital Clínica Bíblica siempre comprometido con el resguardo de su salud y la de sus familiares, se compromete, ante la creciente propagación de la viruela símica a nivel mundial, con la difusión de información veraz relacionada con la prevención de esta enfermedad.
La viruela símica es una enfermedad caracterizada por fiebre, erupción cutánea e inflamación de los ganglios linfáticos. Es causada por un virus de la familia Poxviridae y aunque, en los últimos meses ha tomado relevancia por la propagación en diferentes países, es una enfermedad que se conoce desde 1970 y se detecta principalmente en zonas de la selva tropical de África Central.
“Cabe resaltar que la viruela de mono suele ser una enfermedad autolimitada, esto quiere decir que, en condiciones normales, el sistema de defensas logra eliminar la enfermedad en un período cercano a las 3 semanas, sin embargo, la tasa de letalidad ha sido cercana al 4%”, explicó el Dr. Guillermo Fernández, Jefatura Clínica Médica del Hospital Clínica Bíblica.
Como con cualquier enfermedad, las condiciones previas que tengan los pacientes, especialmente las enfermedades que debilitan el sistema inmune pueden predisponer a complicaciones.
¿Cuáles son los síntomas típicos de la enfermedad?
La viruela símica se caracteriza por un período de incubación de entre seis y 13 días. Posterior a la cual las manifestaciones se dividen en dos fases:
“Las lesiones en la piel inician siendo planas, sin embargo, posteriormente ganan un poco de elevación hasta convertirse en vesículas (lesiones llenas de líquido claro) para finalmente evolucionar a lesiones llenas de líquido amarillento (pus) y costras que se secan y caen”, continuó el Dr. Fernández.
El virus de la viruela símica se transmite por el contacto estrecho con las secreciones de las lesiones cutáneas de una persona infectada o con objetos contaminados recientemente. La transmisión a través de gotículas respiratorias (como sucede con el COVID-19) requiere un contacto cara a cara prolongado.
“El riesgo de contagio es relativamente bajo si se evita el contacto estrecho con personas infectadas (usualmente pacientes con antecedente reciente de viajes internacionales con síntomas), lo cual representa una ventaja si se compara, por ejemplo, con el caso de la reciente pandemia por COVID-19”, agregó el especialista.
La prevención es la estrategia más efectiva. Esté atento a la aparición de los síntomas en personas que entraron en contacto con alguien infectado y consulte rápidamente en caso de que dichos síntomas se presenten.
Le ofrecemos una guía de consejos en caso de que un familiar o allegado sea diagnosticado con viruela símica:
Ante cualquier síntoma que le haga sospechar no dude consultar a nuestros especialistas, llamando al 2522-1000.